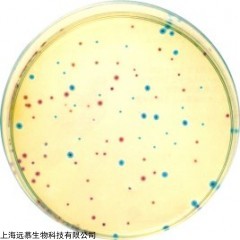

产品简介
MS培养基含维生素,该培养基起源于White培养基,最初是为了种植烟草的愈伤组织而开发的。与White培养基相比,所有成分的浓度都增加了。
公司简介
上海远慕生物科技有限公司是一家集研发、销售、定制合 成于一体的专业试剂公司,我们的团队由具有资深行业背景和丰富市场经验的专业人士组成,致力于向国内外相关大专院校和科研机构提供高品质的化学产品,我司 既能满足研发类客户对产品种类、包装、纯度的特殊要求,也能满足企业从小试、中试到规模化的各个阶段的综合需求。
展开
产品说明
中文名称:
MS培养基含维生素
英文名称:Murashige & Skoog medium including vitamins
规格:50l/100l
品牌:Duchefa
MS培养基含维生素产品描述:MS(Murashige & Skoog)培养基是最常用的组织培养基,已经开发出许多改良形式。该培养基起源于White培养基,最初是为了种植烟草的愈伤组织而开发的。与White培养基相比,所有成分的浓度都增加了。增加到50-60 mM的氮会明显刺激烟草细胞的生长,但是80 mM和更高的浓度显然对细胞不利。所有其它元素(尤其是大量元素)的增加也刺激了愈伤组织的生长。由于矿物质的浓度很高,MS培养基是非常丰富和含盐量高的培养基,对于某些植物物种可能太“咸”。为避免此问题,MS培养基通常与全浓度的微量元素一起使用,而大量元素的浓度分别为浓度的一半或四分之三。有时,原来的MS培养基种维生素被Linsmaier和Gamborg B5培养基中的维生素所取代,因为植物对硫胺素的需求量较大。Duchefa提供多种MS 培养基供您选择。
产品形式:固体
MS培养基含维生素保存建议:建议收到产品后,按照说明书保存建议存放。
其他:Duchefa Biochemie B.V.于1989年成立于荷兰的哈勒姆市。专门研究和供应植物生物技术中使用的培养基和化学品,并且有非常严格的安全要求和质量标准。用于植物生物技术的产品总数已达400多种,主要包括用于植物分子生物学和种子健康测试的培养基,生长调节剂,抗生素,胶凝剂,底物和化学品。更有侧重于植物病理学用途的产品,包括20多种用于测试各种农作物种子上病原体的培养基。
本页产品地址:http://www.geilan.com/sell/show-9356210.html

![]()

 免责声明:以上所展示的[ MS培养基含维生素]信息由会员[上海远慕生物科技有限公司]自行提供,内容的真实性、准确性和合法性由发布会员负责。
免责声明:以上所展示的[ MS培养基含维生素]信息由会员[上海远慕生物科技有限公司]自行提供,内容的真实性、准确性和合法性由发布会员负责。